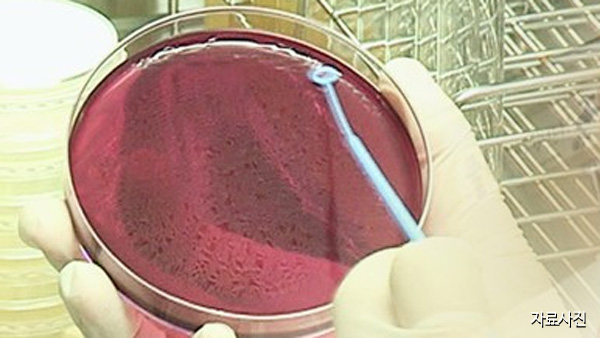
미국 17개주서 한국산 팽이버섯 먹고 사망·식중독

질병통제예방센터 CDC와 식품의약국 FDA에 따르면, 선홍푸드라는 업체가 미국 내에서 유통한 팽이버섯이 리스테리아균에 오염돼 지난 2016년 11월부터 지난해 12월까지 17개 주에서 36명이 식중독에 걸렸다고 밝혔습니다.
질병통제예방센터는 캘리포니아, 하와이, 뉴저지 주에서 4명의 사망자가 나왔고, 임산부 2명은 유산했다고 밝혔습니다.
식품의약국은 선홍푸드에 대해 긴급 회수 명령을 내렸고, 질병통제예방센터는 조사가 끝날 때까지 '한국산'이라고 표시된 팽이버섯은 먹지 말라고 당부했습니다.
(해당 제품에 대한 정보는 아래 사이트에서 확인할 수 있습니다.
https://www.cdc.gov/listeria/outbreaks/enoki-mushrooms-03-20/index.html https://www.fda.gov/safety/recalls-market-withdrawals-safety-alerts/sun-hong-foods-inc-recalls-enoki-mushroom-because-possible-health-risk )

당신의 의견을 남겨주세요